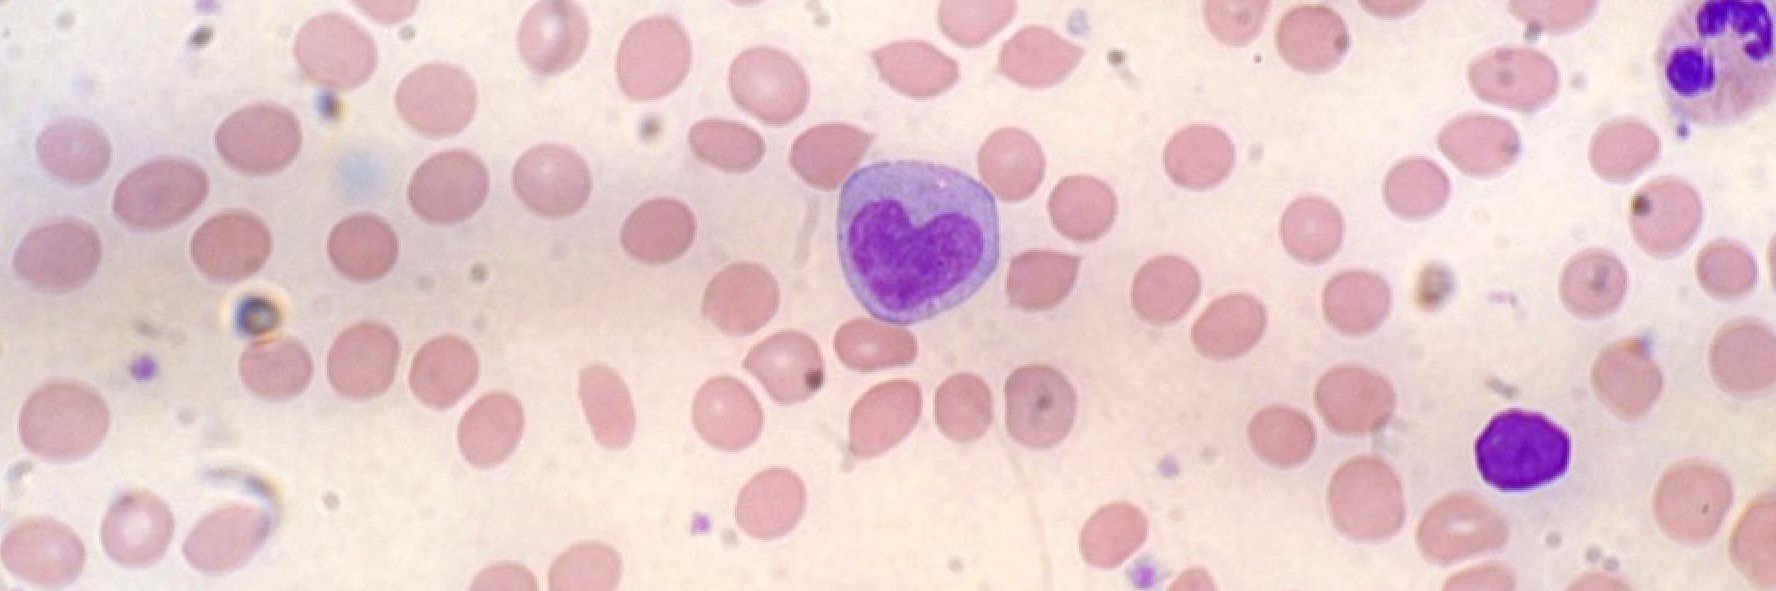
Caroline Watson banner

ทวีตที่ปักหมุด

📢Clonal hematopoiesis driven by mCAs📢What fitness effects do mCAs confer to our blood cells?🩸 How often do they occur? Does an mCA’s fitness correlate with blood cancer risk?🔎Read mine & @jrblundell's latest paper @NatureGenet to find out (& more!):👉🔗rdcu.be/dlRRr

English